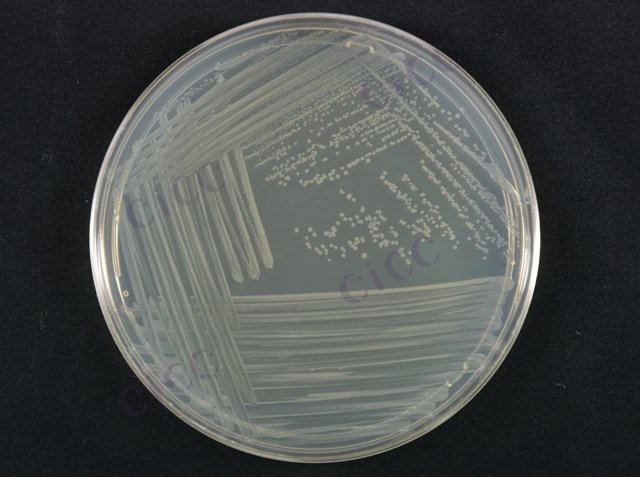
肺炎克雷伯氏菌 Klebsiella pneumoniae CICC 10870 Klebsiella pneumoniae

肺炎克雷伯氏菌 Klebsiella pneumoniae CICC 10870 Klebsiella pneumoniae
-
肺炎克雷伯氏菌 Klebsiella pneumoniae CICC 10493 Klebsiella pneumoniae
CICC 10493 | 见证书
-
肺炎克雷伯氏菌 Klebsiella pneumoniae CICC 10781 Klebsiella pneumoniae
CICC 10781 | 见证书
-
肺炎克雷伯氏菌 Klebsiella pneumoniae CICC 21519 Klebsiella pneumoniae
CICC 21519 | 见证书
-
肺炎克雷伯氏菌 Klebsiella pneumoniae CICC 25387 Klebsiella pneumoniae
CICC 25387 | 见证书
-
肺炎克雷伯氏菌 Klebsiella pneumoniae CICC 25388 Klebsiella pneumoniae
CICC 25388 | 见证书
-
肺炎克雷伯氏菌 Klebsiella pneumoniae CICC 25389 Klebsiella pneumoniae
CICC 25389 | 见证书
-
肺炎克雷伯氏菌 Klebsiella pneumoniae CICC 25390 Klebsiella pneumoniae
CICC 25390 | 见证书

说明书下载: 菌种说明书 打管说明书
您正在浏览的产品:肺炎克雷伯氏菌 Klebsiella pneumoniae CICC 10870
手机版:肺炎克雷伯氏菌 Klebsiella pneumoniae CICC 10870
本公司销售的所有产品仅供实验科研使用,不用于人体及临床诊断。
适用于食品、水样、临床及环境样本中肺炎克雷伯氏菌的检测,包括传统分离培养与分子生物学检测方法[1]。
包含生化鉴定(如VITEK系统)、PCR扩增技术及血清学分型,其中PCR方法通过特异性引物检测靶基因,检测周期缩短至4-6小时[1]。
传统培养法检出限为10² CFU/g,PCR法灵敏度达10¹ copies/μL,定量限需根据标准曲线确定[1][6]。
需包含阳性质控菌株(如ATCC 13883)和阴性质控菌株,临床样本需在采样后2小时内处理,冷冻保存需-70℃以下[6][9]。
1. 样本前处理:增菌培养18-24小时(37℃)
2. DNA提取:煮沸法或试剂盒提取
3. PCR扩增:退火温度55-60℃,循环数35-40次[1][6]。
需严格区分环境分离株与临床毒力株,高毒力株需增加毒力基因检测(如rmpA、magA);多重耐药株需进行ESBLs表型确认[9][10]。
以上信息仅供参考,请以相应标准的原文为准!